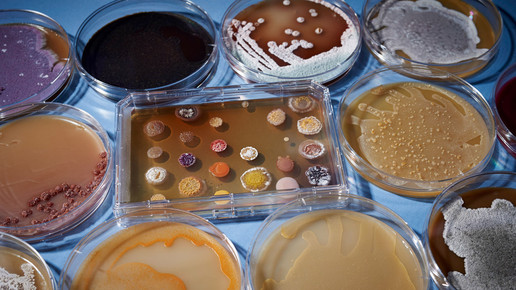

2030: Antibiotikaverbrauch steigt um 200 Prozent
Bakterien werden öfter gegen Antibiotika unempfindlich, weshalb verstärkt Reserve-Wirkstoffe eingesetzt werden. Was wiederum mehr Resistenzen zur Folge hat. Ein gefährlicher Kreislauf droht, wie Forscher mit einer neuen Auswertung belegen.
Der weltweite Antibiotikaverbrauch ist einer Hochrechnung zufolge in den vergangenen 15 Jahren um rund 65 Prozent gestiegen. Besonders in wirtschaftlich aufstrebenden Ländern sei die Zunahme „dramatisch“, berichten Wissenschaftler um Eili Klein vom US-Forschungszentrum Center for Disease Dynamics, Economics & Policy (CDDEP).
Die Forscher hatten auf Basis von Verkaufsdaten den Verbrauch von Antibiotika in 76 Ländern zwischen 2000 und 2015 untersucht und daraus auf weltweite Trends geschlossen. Der Gesamtkonsum stieg demnach von 21,1 Milliarden definierten Tagesdosen (DDD) im Jahr 2000 auf 34,8 Milliarden 15 Jahre später. Dieser von der Weltgesundheitsorganisation (WHO) statistische Wert wurde geschaffen, um mit einheitlichen Angaben auf den Verbrauch eines Wirkstoffes schließen zu können. Die vom Arzt empfohlene oder verschriebene Dosis kann davon abweichen.
Der durchschnittliche tägliche Verbrauch pro 1000 Einwohner stieg um 39 Prozent von 11,3 auf 15,7 definierte Tagesdosen, wie die Forscher im Fachjournal „Proceedings“ der US-nationalen Akademie der Wissenschaften (PNAS) berichten. In ärmeren und aufstrebenden Ländern nahm der Gesamtverbrauch sogar um 114 Prozent und der durchschnittliche tägliche Verbrauch pro 1000 Einwohner um 77 Prozent zu. Der Unterschied beider Werte liegt unter anderem im Bevölkerungswachstum begründet.
Während im Jahr 2000 noch Länder wie Frankreich, Neuseeland, Spanien und Hongkong beim mittleren Verbrauch pro 1000 Einwohner an der Spitze lagen, waren es 15 Jahre später Länder wie die Türkei, Tunesien, Algerien und Rumänien. In den reichen Industrieländern nahm der Gesamtverbrauch nur um sechs Prozent zu, der durchschnittliche tägliche Verbrauch pro 1000 Einwohner sank im Mittel sogar um vier Prozent. Dies galt für Länder wie die USA, Kanada und Frankreich – für Deutschland hingegen wurde ein leichter Zuwachs erfasst.
Weltweite Zuwächse gab es nicht nur bei vielfach eingesetzten Wirkstoffen wie Penicillin, sondern auch bei sogenannten Reserve-Antibiotika wie Linezolid und Carbapenemen, die nur zum Einsatz kommen sollten, wenn kein anderes Mittel mehr hilft.
Bis 2030 könnte der Gesamtverbrauch an Antibiotika den Forschern zufolge weltweit um bis zu 200 Prozent steigen. Resistenzen gegen Antibiotika gelten inzwischen als großes Problem. Mit einer verstärkten Verwendung der Wirkstoffe könnte sich diese Entwicklung weiter verschärfen, wird befürchtet, da mit zunehmendem Kontakt von Bakterien mit Antibiotika auch das Risiko zunimmt, dass sie unempfindlich dagegen werden. In Europa treten zum Beispiel schon jetzt immer mehr Resistenzen gegen Carbapeneme auf.
„Wir müssen entschlossen handeln und wir müssen jetzt handeln, umfassend, um die Effektivität von Antibiotika zu bewahren“, sagte CDDEP-Direktor Ramanan Laxminarayan, Mitautor der Studie. „Das beinhaltet Lösungen zur Senkung des Verbrauchs wie Impfungen oder Verbesserungen der Infrastruktur, besonders in Entwicklungsländern.“

APOTHEKE ADHOC Debatte